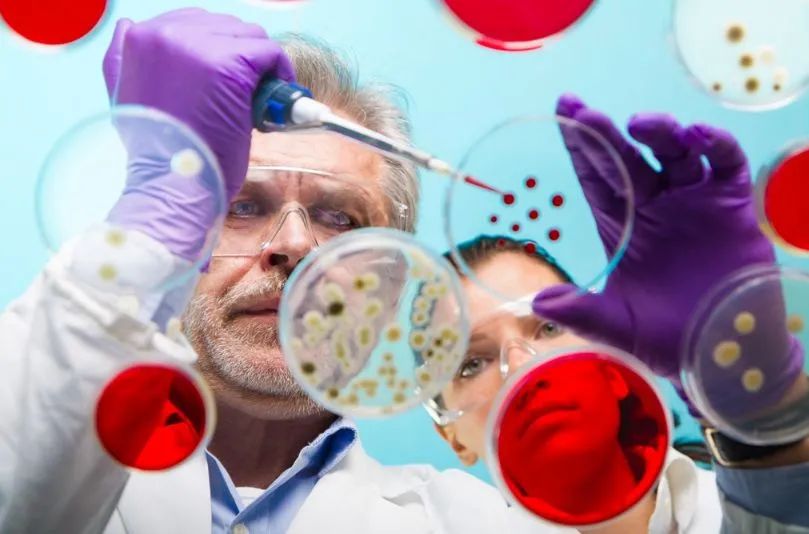

反复移植失败目前尚无统一定义,一般认为IVF治疗超过 3个移植周期或者累计移植10个以上高评分胚胎而未能怀孕就称之为反复移植失败。随着实验室技术的提高和囊胚培养单胚移植的普及,有人认为累计移植4-6枚高评分胚胎,或2-3枚囊胚仍然不能怀孕即可诊断为反复移植失败。
临床上,反复移植失败的原因极其复杂,常混合有多种因素,是困扰辅助生殖医生的一大难题。胚胎发育潜能差、子宫环境不良、子宫内膜接受性差、输卵管积水或者免疫性出现异常都是导致反复移植失败的重要原因。可以从“内因”和“外因”两个角度来考虑对反复移植失败的应对策略。
所谓“内因”即“胚胎质量”,质量好的胚胎可以种植于子宫内膜,也可以种植在内膜以外的地方,如输卵管、卵巢、子宫瘢痕处等。因此,胚胎质量是着床成功的关键因素。胚胎质量与双方的遗传特性有关,希望通过调整促排方案来改善胚胎质量的可能性并不大,一般只能在已有的胚胎中进行选择。现有的胚胎评分标准只是形态学分析,对于胚胎的发育潜力以及遗传物质正常与否却无从判断。因此,对于反复移植失败的患者进行囊胚培养以及PGS来进行胚胎筛选,淘汰发育潜力差或者有染色体异常的胚胎,可以提高移植的成功率。高效的胚胎培养体系及Time Lapse技术有助于改善胚胎发育及选择的精准度。
相对于“内因”的简单,“外因”似乎更加复杂。
宫腔异常:宫腔是胎儿成长的场所,良好的宫腔环境是胚胎着床的重要保证。经阴道超声检查可以发现大部分的子宫异常,如内膜息肉、粘膜下子宫肌瘤、宫腔粘连或者宫腔畸型,宫腔镜检查可以明确诊断,并进行相应的手术处理,可以有效提高下一周期的胚胎种植率。
子宫内膜容受性:临床上B超广泛应用于测量子宫内膜厚度、形态、宫腔形态及血流指数等来评估子宫内膜容受胚胎的能力。内膜过薄、子宫动脉血流阻力升高会在一定程度上影响胚胎的着床,口服阿司匹林以及皮质激素可以提高这部分患者的移植成功率。
输卵管积水:输卵管积水含有各种毒性物质,如果不予处理,积水可能会返流到宫腔,会“冲走”“淹死”胚胎,其炎性物质会干扰胚胎着床,从而导致胚胎种植的失败。可以对有积水的输卵管进行结扎、栓塞或切除,以防止积液对着床的影响。
免疫异常:全身或子宫内膜局部自然杀伤细胞的活性异常升高,主动免疫缺陷的患者缺乏“封闭抗体”,都将导致胚胎易受到免疫攻击,不利着床。目前对免疫异常尚缺乏明确有效的治疗方法,主动免疫、免疫抑制剂或者皮质激素治疗褒贬不一。
另外,我们可以通过调整胚胎移植的策略来提高胚胎移植成功率,使用长效GnRH-a进行降调节后的激素替代治疗可以改善宫腔环境,提高胚胎着床率,对子宫内膜异位症以及反复移植失败的患者有较好的疗效。
体外受精-胚胎移植是一个系统工程,除了以上原因外,还应考虑医生临床经验及手术操作、实验室设备及管理、病人心理素质及医患默契程度等因素,做好每一个细节才能有利最后的成功。
本文转载自彭献东医生科普文章,版权归彭献东医生所有,如有侵权请联系小编删除









